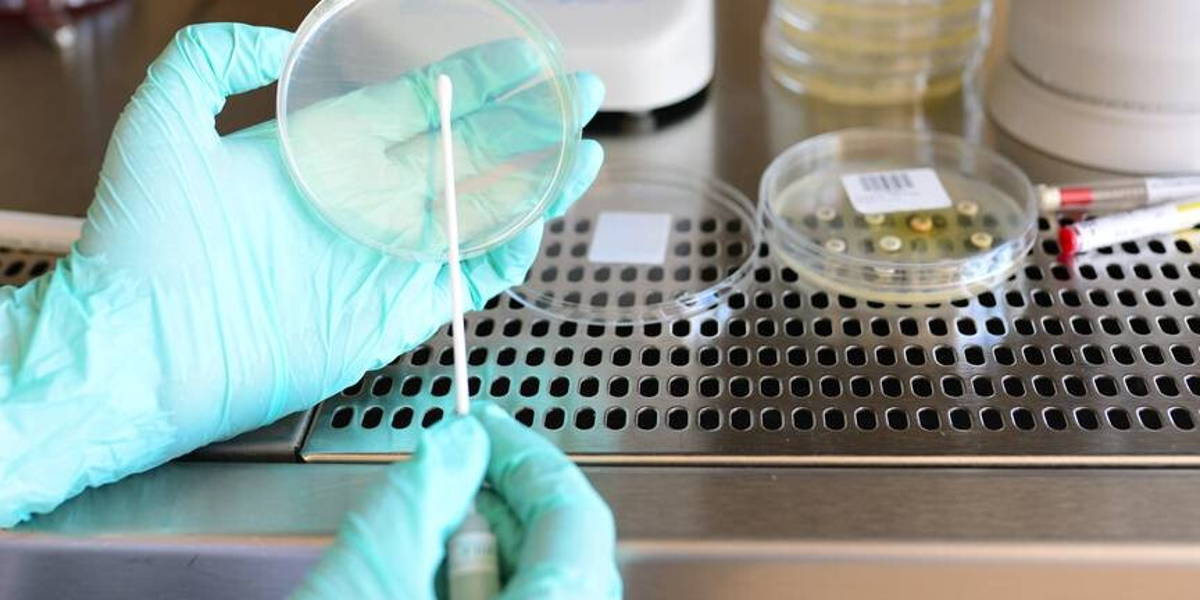
Laboratorium-klinische-pathologie

Het Bravis ziekenhuis (Bergen op Zoom/Roosendaal) en het Elisabeth-TweeSteden Ziekenhuis (ETZ, Tilburg/Waalwijk) hebben hun laboratoria pathologie ondergebracht in een besloten vennootschap met de naam Pathologie Zuid-West Nederland. Ook de vakgroepen klinische pathologie fuseren. De veranderingen zijn per 1 januari 2022 ingegaan. Het nieuwe pathologiecentrum kan onder meer AI efficiënter toepassen bij het beoordelen van biopten.
Met de fusie willen de twee ziekenhuizen de toekomstbestendigheid verbeteren van zowel de vakgroepen als de beide laboratoria klinische pathologie. Dat is volgens Bravis en ETZ goed nieuws voor patiënten waarvan weefsels en cellen door de pathologen op afwijkingen worden onderzocht. Door het samenvoegen en delen van de beschikbare kennis en kunde kan beter ingespeeld worden op toekomstige kwaliteitseisen. De fusie is een eerste antwoord op de schaalvergroting die nodig is.
Stijgende volumenormen pathologie
Door de schaalvergroting voldoen de ziekenhuizen beter aan de geadviseerde, stijgende volumenormen. Dat is van groot belang in de diagnostische zorg. Patiënten hebben direct baat bij een zo hoog mogelijke kwaliteit. Beide laboratoriumlocaties blijven behouden voor het direct contact met de ziekenhuisspecialisten en huisartsen.
Bianka Mennema, voorzitter raad van bestuur Bravis, spreekt over een belangrijke stap voor de inhoudelijke ontwikkeling van de pathologie. “Niet alleen brengen we beide vakgroepen en laboratoria samen, we lanceren tevens een nieuw ICT-platform waarmee digitale pathologie wordt gefaciliteerd. De werkzaamheden van de pathologen zijn daardoor niet meer plaatsgebonden. Dit is wat ons betreft de start van verdergaande regionalisering in de pathologie in Zuid-West Nederland.”
Optimaal AI inzetten
In de nieuwe bv zijn vanaf de jaarwisseling 10 pathologen werkzaam. Het streven is om op termijn door te groeien naar 20 à 25 pathologen, aldus Gerard van Berlo, bestuurder ETZ. “Daarmee willen we een solide basis creëren voor toekomstige, technische ontwikkelingen. Het nieuwe platform maakt het voor de pathologen mogelijk om optimaal gebruik te maken van AI-toepassingen bij het beoordelen van de biopten, waardoor ze sneller uiterst betrouwbare diagnoses kunnen stellen.”
Bart Bliek is medisch directeur van Pathologie Zuid-West Nederland. Hij verwacht dat de geïntegreerde vakgroep beter invulling kan geven aan subspecialisaties in het vak. “Omdat we meer collega’s hebben, kunnen we ons elk verder specialiseren op een bepaald onderwerp. We verdiepen daarmee onze expertise, en dat is in het belang van de patiënten in onze beide ziekenhuizen.”